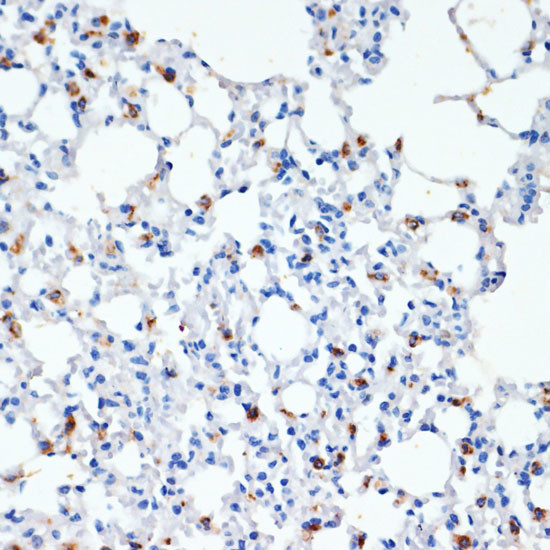
SFTPC Antibody in Immunohistochemistry (Paraffin) (IHC (P))

Search
Invitrogen
SFTPC Polyclonal Antibody
{{$productOrderCtrl.translations['antibody.pdp.commerceCard.promotion.promotions']}}
{{$productOrderCtrl.translations['antibody.pdp.commerceCard.promotion.viewpromo']}}
{{$productOrderCtrl.translations['antibody.pdp.commerceCard.promotion.promocode']}}: {{promo.promoCode}} {{promo.promoTitle}} {{promo.promoDescription}}. {{$productOrderCtrl.translations['antibody.pdp.commerceCard.promotion.learnmore']}}
图: 1 / 6
SFTPC Antibody (PA5-76631) in IHC (P)






产品信息
PA5-76631
种属反应
已发表种属
宿主/亚型
分类
类型
抗原
偶联物
形式
浓度
规格
纯化类型
保存液
内含物
保存条件
运输条件
RRID
产品详细信息
The antibody was affinity-purified from rabbit antiserum by affinity-chromatography using epitope-specific immunogen and the purity is > 95% (by SDS-PAGE).
靶标信息
This gene encodes the pulmonary-associated surfactant protein C (SPC), an extremely hydrophobic surfactant protein essential for lung function and homeostasis after birth. Pulmonary surfactant is a surface-active lipoprotein complex composed of 90% lipids and 10% proteins which include plasma proteins and apolipoproteins SPA, SPB, SPC and SPD. The surfactant is secreted by the alveolar cells of the lung and maintains the stability of pulmonary tissue by reducing the surface tension of fluids that coat the lung. Multiple mutations in this gene have been identified, which cause pulmonary surfactant metabolism dysfunction type 2, also called pulmonary alveolar proteinosis due to surfactant protein C deficiency, and are associated with interstitial lung disease in older infants, children, and adults. Alternatively spliced transcript variants encoding different protein isoforms have been identified.
仅用于科研。不用于诊断过程。未经明确授权不得转售。
生物信息学
蛋白别名: BRICHOS domain containing 6; PSP C; pulmonary surfactant apoprotein-2 SP-C; pulmonary surfactant protein (SP5) precursor; pulmonary surfactant proteolipid precursor; Pulmonary surfactant-associated protein C; Pulmonary surfactant-associated proteolipid SPL(Val); SFTP 2; SP C; SP-C; SP5; surfactant associated protein C; Surfactant protein C; Surfactant pulmonary-associated protein C; Surfactant, pulmonary-associated protein C; unnamed protein product
基因别名: BRICD6; pro-SpC; PSP-C; Sftp-2; SFTP2; SFTPC; SMDP2; SP-C; SP5; SPC
UniProt ID: (Human) P11686, (Rat) P11685
Entrez Gene ID: (Human) 6440, (Mouse) 20389, (Rat) 50683